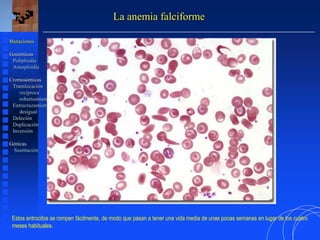
La anemia falciforme
Mutaciones
Genómicas
Poliploidía
Aneuploidía
Cromosómicas
Translocación
recíproca
robertsoniana
Entrecruzamiento
desigual
Deleción
Duplicación
Inversión
Génicas
Sustitución
Estos eritrocitos se rompen fácilmente, de modo que pasan a tener una vida media de unas pocas semanas en lugar de los cuatro
meses habituales.

Este documento trata sobre las mutaciones y la variación genética. Explica los tipos de mutaciones como genómicas, cromosómicas y génicas. Describe síndromes como el síndrome de Down, causado por la trisomía del cromosoma 21, y el síndrome de Turner, causado por la monosomía del cromosoma X. También analiza otros tipos de mutaciones como las translocaciones cromosómicas y su relación con enfermedades como la leucemia mieloide aguda.